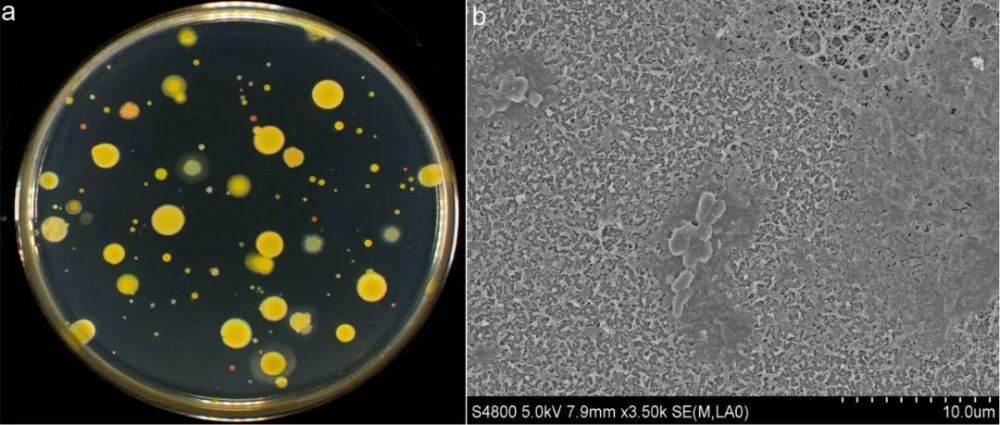

从事饮用水安全研究多年,发现在亲友圈最是有名。“要不要装净水器?装什么牌子的净水器?净水器的功效如何?…”已经成为笔者被寒暄的私人定制。很显然,民众正从“能吃饱”向“要过好”的过程转变,对美好生活和健康饮水有日益增长的需求。
但是,面对市售、自媒体、直播等各种渠道让人眼花缭乱的净水产品,
你,慌不慌?
社会进步的小标签——净水器
水是生命之源,约占人体组成的70%,在婴儿体内甚至高达80%。水作为重要的溶剂,参与人体内各种生化反应。健康的人平均每日需饮水约2l,才能维持正常的新陈代谢,俗称“八杯水”(图1)。但是,随着环境污染的加剧,饮用水水源地被严重破坏,污染物种类和水平不断增加;同时,社会进步、物质富足,即使达标的饮用水也可能满足不了民众对其精益求精的要求(如口感、抗生素残留等)。因此,家用净用器作为用户自定义、终端深度处理设备应运而生,并蓬勃发展。

图1 水占人体的比例及科学饮水(图片来源于网络)
知己知彼——家用净水器的种类及工艺
要了解家用净水器的功能及效果,需先明白其工艺原理。目前市售的主流家用净水器主要由pp棉(初级过滤)、活性炭或其他复合吸附材料(二级过滤)、以及膜材料(核心过滤)多级串联而成,属复合型净水器(图2a)。
活性炭材料因具有极高的比表面积及发达的内部孔隙,能高效吸附水中的有机物、嗅味物质以及余氯等化学物质。膜材料根据膜孔径的大小主要分为微滤(0.05-5 μm)、超滤(5-100 nm)、纳滤(1-10 nm)、及反渗透(
其他类型净水器主要包括软化净水器和功能型净水器。前者是在复合型净水器的基础上增加了阴/阳离子交换树脂组件,可以去除水中的钙、镁等离子,降低水质硬度也进一步提升饮水的口感。功能型净水器则内置某些“特殊功能”的组件,往往价格更加昂贵,常见如矿化/磁化净水器、电渗析净水器等。对于该类净水器的实际作用,笔者建议大家秉持净水器本质是净水产品,而非保健产品的原则,不能盲从。尤其对于“特殊功能”材料,自身可能会释放对人体有害物质,应予以重视。

图2 净水器(a)和膜孔径分类及其去除的物质(b)(图片来源于网络)
看不见的凶手——净水器的微生物污染
民众对于看得见的物化污染(色/浊度、嗅味)通常敏感,往往忽略看不见的微生物污染。已有科学研究表明,居民家用净水器处理出水的总细数超标率(>100 cfu/ml)为13.2-87.5%。近来,中国科学院城市环境研究所/厦门大学于鑫团队研究发现,净水器内部活性炭及膜组件表面附着的微生物可达102-106cfu/g(图3),总活细菌量为103-105copies/ml(pma-qpcr检测)。此外,大肠杆菌escherichia coli(10-106copies/g)和铜绿假单胞菌pseudomonas aeruginosa(10-105copies/g)等水传病原菌也有不同程度检出(qpcr检测);高通量测序进一步揭示了大肠杆菌(0-6.26%)、分枝杆菌mycobacterium mucogenicum(0.01-3.46%)、及铜绿假单胞菌(0-0.16%)在净水器不同组件内的分布特征。
复合型净水器的活性炭和膜组件可吸附、截留微生物,消耗余氯等化学物质,提升饮水的物化指标及口感。但其对于微生物仅为物理作用,并没有完全杀灭。随着净水器使用时间的延长或使用方式不科学,微生物在活性炭和膜组件中将重新增殖。此外,笔者在采样调研中发现,很多用户的净水器滤芯几年甚至十几年从未更换,净水器超负荷运行,俨然成为微生物的“富集天堂”,一旦发生泄露将严重威胁民众的健康。所以,安装家用净水器后,科学、合理的净水器使用及维护同样重要。
图3 净水器的微生物污染(a)r2a平板培养(b)扫描电镜拍摄
最后,想要送给大家一些话:
要不要装净水器?可以要,但不是必须要。净水器只是锦上添花的产品,符合我国《生活饮用水卫生标准》的管网末端出水也是安全的。
装什么牌子净水器?为了避免软广,在此仅做工艺推荐。活性炭滤芯不是越多越好,膜孔径不是越小越好,笔者建议选择结构紧致密实的活性炭+超/纳滤的复合型净水器。
净水器的功效如何?净水器本质是净水产品,而非保健产品,不要盲从其“功能性”。另外,一定要科学的使用和维护。净水器长期未使用应先排空,多次反冲后再正常使用。
最后,定时换滤芯!换滤芯!换滤芯!
参考文献:
1.wenfang lin, chengsong ye, lizheng guo, dong hu, xin yu*. analysis of microbial contamination of household water purifiers. applied microbiology and biotechnology, 2020, 104: 4533–4545.
2.hoslett j, massara tm, malamis s, ahmad d, van den boogaert i, katsou e, ahmad b, ghazal h, simons s, wrobel l, jouhara h. surface water filtration using granular media and membranes: a review. science of the total environment, 2018, 639:1268–1282.
3.周昭彦, 胡必杰, 鲍容, 高晓东, 沈燕, 崔杨文, 孙伟, 周晴. 净水器微生物污染状况调查及影响因素分析. 中华医院感染学杂志, 2012, 22: 2580–2582.
4.吴立明, 崔文广, 张昀, 葛国良, 陈哲, 汪国权, 李竹. 上海市家用水质处理器出水水质卫生状况调查. 环境与职业医学, 2012, 29: 475–480.
5.王达伟. 家用净水设备细菌污染及与水接触材料对微生物生长影响的研究, 2017. (学位论文)
作者:林文芳、叶成松、于鑫
来源:中国科学院城市环境研究所










